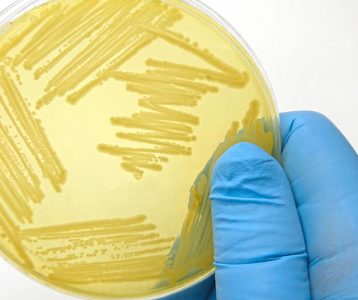
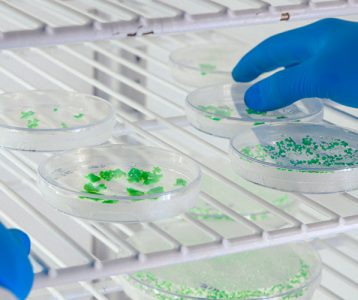
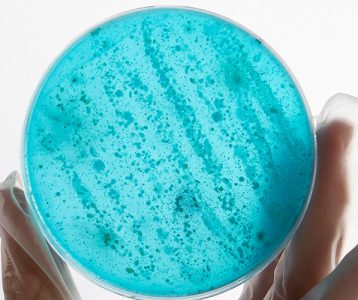

A ameixa é uma fruta nutritiva, versátil e popular no Brasil, tanto na versão in natura quanto seca ou na forma de geleias e sucos. Rica em fibras solúveis e insolúveis, vitaminas e minerais, oferece inúmeros benefícios à saúde. Além de regular o trânsito intestinal, a fruta ajuda a reduzir a ansiedade, aumenta a saciedade, fortalece o sistema imunológico e atua na prevenção do envelhecimento precoce. Consumida com moderação, também pode contribuir para uma alimentação saudável e equilibrada.
De acordo com a nutricionista Pollyana Ayub, professora de Nutrição do Centro Universitário de Brasília (CEUB), a ameixa se destaca por suas características nutricionais. Entre seus principais micronutrientes estão o fornecimento de vitaminas e minerais essenciais como, por exemplo, a vitamina C, que fortalece o sistema imunológico. “Além disso, possui a vitamina A, que melhora a saúde dos olhos e contribui para a imunidade, e o potássio, que auxilia na regulação da pressão arterial”, acentua.
Por conter muitas fibras solúveis e insolúveis, o consumo da ameixa ajuda a equilibrar o funcionamento do intestino, prevenindo e combatendo a constipação devido ao seu efeito laxativo natural. As fibras da fruta também auxiliam no controle dos picos de glicemia, especialmente para pessoas com diabetes ou resistência à insulina. “Ao consumir alimentos ricos em fibras, a exemplo da ameixa, é importante realizar a gestão da constipação intestinal com água para evitar o efeito contrário”, sinaliza a nutricionista.
Na versão seca (com sabor mais adocicado), a ameixa pode auxiliar a reduzir o desejo por doces mais calóricos. Isso é possível devido à presença da fibra solúvel pectina, que atua no aumento da saciedade ao mesmo tempo em que retarda o esvaziamento gástrico.
Por ser um alimento fonte de substâncias antioxidantes, como flavonoides e fenóis, a ameixa tem potencial para proteger as células contra os efeitos dos radicais livres. Esses compostos ajudam a reduzir os impactos de doenças crônicas, a exemplo das cardiovasculares, pois mantêm a saúde das artérias, previnem inflamações e facilitam o relaxamento dos vasos sanguíneos. “Como resultado, melhoram a circulação do sangue e atuam no controle da hipertensão”, observa a especialista.
O consumo regular da ameixa pode contribuir, ainda, para a redução da ansiedade, devido à presença de nutrientes que atuam no equilíbrio do sistema nervoso. A professora explica, ainda, que a composição da ameixa ajuda a manter o bem-estar e a saúde mental, sendo um excelente complemento para uma dieta equilibrada.
Consumo moderado
De acordo com a nutricionista, embora ofereça muitos benefícios à saúde, a fruta deve ser consumida com moderação em algumas situações. Por exemplo, indivíduos com trânsito intestinal acelerado podem experimentar efeitos laxativos mais intensos. Para aqueles com doenças renais, a atenção deve ser voltada ao acúmulo de potássio, que pode levar a alterações no ritmo cardíaco. “Já os diabéticos devem evitar versões de ameixa seca que contenham açúcar adicionado, para não elevar a glicemia”, sugere.
A ameixa pode ser consumida in natura ou incorporada em receitas variadas na forma de geleias, sucos e compotas. Para aproveitar ao máximo os benefícios da fruta, a nutricionista recomenda que seu consumo seja feito sob orientação de um profissional de Nutrição.